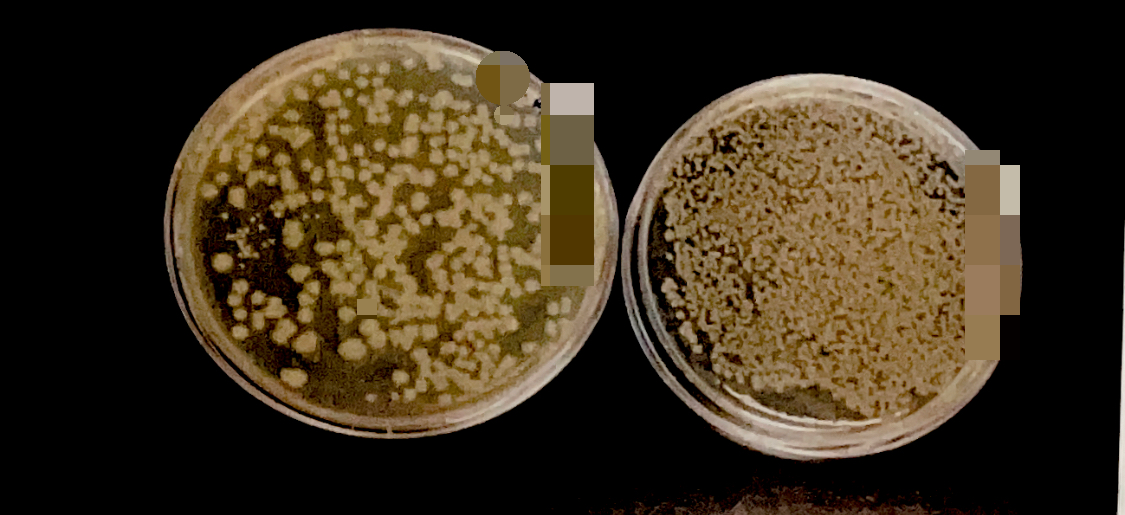

1. 실험 제목 : 세균의 측정 (pour plate method)
2. 실험 일시 :
3. 실험 목적 :
식품 중에 존재하는 미생물의 양은 식품의 종류에 따라 다르지만 무균식품 (통조림) 등을 제외하고는 어떠한 형태로든지 미생물이 존재한다. 일반적으로 식품 중의 생균수는 10^4~10^7/g 정도이다.
다양한 검체 속의 균수는 여러가지 방법으로 측정할 수 있다. 사균, 생균의 구별 없이 총균수를 측정할 수도 있고, 생균수만을 측정할 수도 있다. 다양한 방법 중 각 방법의 장단점을 알고 사용 목적에 따라 적절한 방법을 선택한다.
4. 실험 원리 :
검체 속의 균수는 여러 가지 방법으로 측정할 수 있다. 사균, 생균의 구별 없이 총균수를 측정할 수도 있고, 생균수만을 측정할 수도 있다.
총 균수를 측정할 때는 일정한 부피 내에 존재하는 세균 수를 혈구 계수기 (hemacytometer) 등을 이용하여 현미경 시야에서 세균 수를 직접 세는 방법과, 액체 배지에서의 탁도 (tubidity), 건조 중량 (dry weight) 등의 측정 등 여러 가지 방법이 있다.
또한 생균수는 생균 친화적 염료로 균을 염색한 후 측정하기도 하지만 보통은 균의 증식 능력에 비례하여 배지 상에 형성된 집락 수를 선저하여 생균수를 측정한다.
평판 계수법 (plate count technique)은 가장 보편적으로 쓰이는 방법으로, 살아있는 세균은 colony를 형성하는 것을 전제로 하는 생균수 (viable count) 측정법이다. 따라서 평판 배지 상에 형성된 집락의 수는 시료 내에 포함되어 있는 colony 형성이 가능한 살아있는 세균의 숫자에 관계없이 시료에 포함된 전체 세균의 숫자를 측정하는 방법을 총 세균수 측정법 (total count)라고 한다.
생균수의 측정 방법은 시료를 직접 agar plate에 도말하면 한 개의 세포가 증식하여 생긴 수만 개의 colony가 형성되므로 그 수를 세기 너무 많을 뿐 아니라 colony와 colony가 중복되어 정확한 수를 셀 수 없으므로 시료를 적절하게 희석해서 평판 배지에 접종하여 배양한 수 plate 내에 적절한 수 (30~300) 개의 colony가 골고루 분포되게 하여 colony 수를 측정해야 한다. 형성된 집락의 단위는 CFU(colony forming unit)로 표시하며 반드시 희석 배율이 명시되어야 한다.
5. 실험 재료 :
알코올램프, 백금이, glass spreader, pipett, tip, Macconkey agar plate 10개, E.coli 배양액, PBS, epp tube 5개
conical tube (50ml) + 90ml PBS
6. 실험 방법
-희석
1) E.coli 배양액 피펫을 사용하여 1ml를 취해 9ml PBS가 들어있는 conical tube (50ml)에 넣고 잘 흔들어 1/10배 희석한다.
2) Epp tube에 pipette을 사용하여 PBS 9ml를 취하여 넣고, 1차 희석균액을 10ml 취하여 함께 넣은 후 잘 흔들어 원액의 1/100로 희석
3) 위와 같은 방법으로 1/10^3, 1/10^4, 1/10^5, 1/10^6로 희석하여 희석 균액을 준비
-평판 배지에 옮기기 (표면 평판법을 사용함)
1) 1/10^2, 1/10^3, 1/10^4, 1/10^5, 1/10^6로 희석한 희석 균액을 준비한다.
2) 각각의 희석균액에서 100ul의 희석균액을 고체 배지에 옮긴다.
3) Alcohol이 든 beaker에 있는 glass spreader를 화염 멸균하여 Maconkey agar plate에 옮긴 희석 균액을 배지에 골고루 편다.
4) 37'c에 24시간 배양한다.
-관찰하고 결과 계산하기
1) 배양한 후 집락 (colony) 수가 30-300개의 범위가 되는 희석 배율의 평판배지를 골라 집락의 수를 구한다.
2) 집락의 수에 희석 배율을 곱하면 원래의 시료 1ml (또는 1g) 에 존재하는 세균 중 집락 형성 능력이 있는, 즉 살아있는 세균의 평판 수를 구할 수 있다.
*희석액을 0.1ml 접종한 경우에는 동일한 희석액 1ml 가한 경우보다 10배를 더 곱해야 한다.
7. 실험 결과 :
이번 실험은 살아있는 균을 배양시켜 형성된 콜로니 수를 측정하였고 연속 희석법으로 배양액을 희석해 세균수를 추정하였다.
10^-1, 10^-2, 10^-3, 10^-4, 10^-5 배 희석한 배양액을 각각 100ul씩 배지에 접종하였고 30~300개 사이의 콜로니 수를 가진 배양액은 10^-5 희석액으로 우리 조는 265개의 콜로니가 관찰되었다.
CFU/ml = 265 x 10^5 x 10 = 2.65 x 10^8
(100ul = 0.1ml, 부피보정 = 10)
8. 고찰 :
콜로니란 single bacteria에서 유래한 눈으로 볼 수 있는 균체의 집합체를 말한다. 살아있는 균을 측정하는 방법은 크게 두 가지 막여과법 (filtration)과 연속 희석법 (serial dilution method)가 있다.
막여과법은 액체 내에 존재하는 미생물을 여과막으로 거른 후 이를 배양하여 미생물의 존재 유무나 개체수를 측정하는 일종의 생균측정법이다.
멸균된 여과장치에 있는 여과막에 액체 시료를 통과시킨 후 배지에 배양하여 자라난 콜로니를 측정한다. 막여과장치는 미생물의 생장에 영향을 주지 않는 재질이어야 한다.
여과막은 막여과장치의 직경에 맞는 크기를 선택하고 공극의 크기를 고려해야 한다.
연속희석법은 계열희석, 단계희석이라고도 하는데 희석 조작의하나로 혈청 등의 검체의 농도를 단계적으로 엷어지도록 연속적으로 희석하는 것이다.
총균수 (살아있는 균 + 죽은 균)를 측정하는 방법은 흡광도, 혈구계수기 방법이 있다. 흡광도는 미생물 배양액의 흡광도가 일정 범위에서는 미생물의 밀도와 비례한다는 것을 이용한 방법으로 세균 효모 및 단세포, 조류 등에 사용할 수 있다.
배지에 세포 이외의 고형물이 없는 경우에 사용할 수 있는 가장 간단한 방법이다. 분광광도계를 사용하여 시료가 흡수된 빛의 세기를 측정하며 배지 성분에 의한 흡광을 최소화하는 파장인 550-700nm에서 측정한다. 배지가 투명하고 고형물과 측정하는 파장의 빛을 흡수하는 물질이 없어야 한다. 이 방법은 균체 수 또는 균체량과 흡광도 관계를 나타내는 표준 곡선이 직선일 때만 유효하다.
현미경 측정법은 특별히 고안된 계수기를 사용하여 일정 부피에 존재하는 모든 세포의 수를 세는 방법으로 세균, 효모 등 단세포 미생물의 수를 세는데 적합하다. 액체 배양한 시료를 직접 사용하거나 염색한 균수를 측정하며 세균의 계수에는 Petroff-Hausser 계수기를 사용하고 효모의 계수에는 Thoma의 혈구 계수기를 사용한다. 현미경 측정법을 사용하면 신속하게 세포의 수를 셀 수 있으며 세포의 크기와 형태에 관한 정보도 얻을 수 있다. 평판 배양법으로는 특정 조건에서 증식할 수 이는 미생물만 측정할 수 있으나 현미경 계수법은 시료에 존재하는 모든 미생물을 측정할 수 있다. 0.1% 메틸렌 블루로 염색하면 산 세포와 죽은 세포를 쉽게 구별할 수 있다.
평판배양법의 결과가 통계적으로 신뢰성을 갖기 위해서는 한 평판에 형성된 집락의 수가 30~300 정도여야 한다. 따라서 시료의 미생물 수가 많을 때는 시료를 10배수 연속희석법 (serial decimal dilution)으로 적절히 희석하여 집락의 수가 이 범위에 있도록 하여야 한다.
측정 결과는 집락 형성 단위 CFU(colony-forming unit)로 표시한다. 살아있는 한 개의 미생물 세포가 한 개의 집락을 형성한다는 가정하에 균수를 측정하나 실제는 한 개 이상의 생균의 하나의 집락을 형성하기도 하고 살아있는 세포 중 일부는 집락 형성을 못하기도 하므로 ml 혹은 g 당 세균수가 아닌 CFU 단위를 사용한다.
9. 참고문헌
https://microbeonline.com/pour-plate-method-principle-procedure-uses-dis-advantages/
Pour Plate Method: Procedure, Uses, (Dis) Advantages • Microbe Online
One of the best methods to determine the number of bacteria present per mL of liquid broth/specimen.
microbeonline.com
https://www.nexcelom.com/applications/cell-counting-method-selection/cell-counting-method/
Cell Counting Method | Nexcelom Bioscience
Cell counting methods using cell counting assays and systems are used in biotechnology for assessing cell concentrations.
www.nexcelom.com
***** 바뀐 기준으로 집락의 수 30~300 을 -> 15~300으로 정정합니다.*****
제 블로그를 찾아주셔서 감사합니다!
도움이 되셨다면 댓글 혹은 공감 부탁드립니다.✒️
'실험노트 > 일반미생물학 실험' 카테고리의 다른 글
| [실험노트] 일반미생물학 실험 9. 미생물의 성장에 영향을 미치는 환경적 요인 - 온도, pH 에 대한 영향 (1) | 2023.05.11 |
|---|---|
| [실험노트] 일반미생물학 실험 8. 미생물의 번식 측정 O.D 측정 (0) | 2023.05.01 |
| [실험노트] 일반미생물학 실험 6. 현미경을 이용한 미생물의 관찰 (0) | 2023.04.30 |
| [실험노트] 일반미생물학 실험 5. 현미경을 이용한 미생물의 관찰 (0) | 2023.04.14 |
| [실험노트] 일반미생물학 실험 4. 식품 등의 재료로부터 미생물의 순수 분리 (0) | 2022.08.31 |
댓글